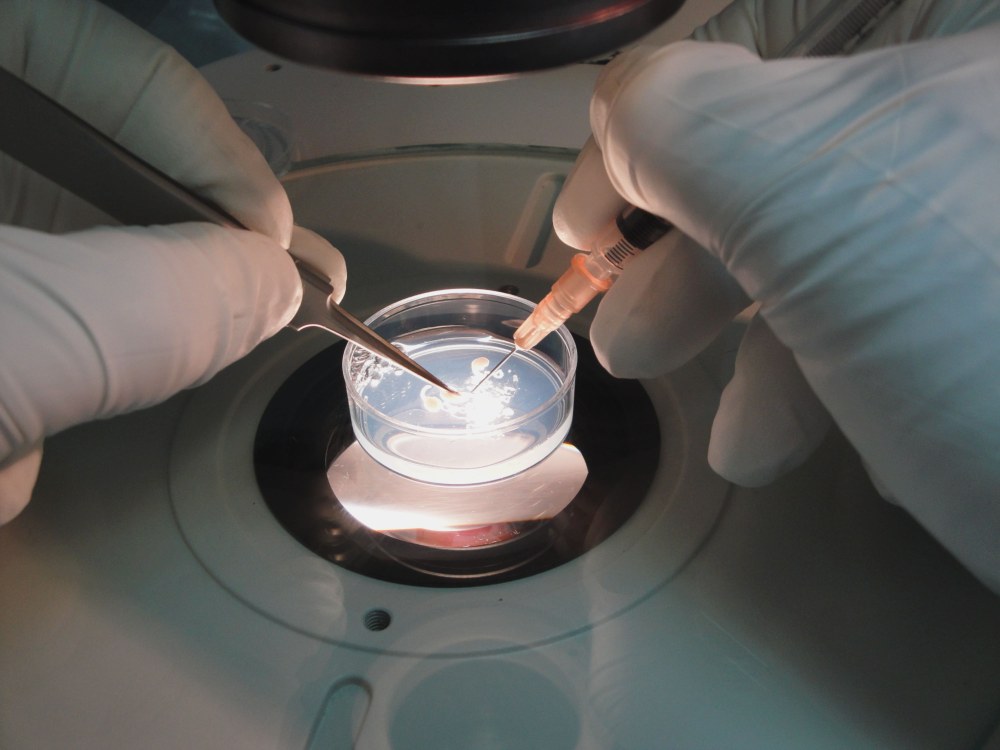

Кріоконсервація сперми є ефективним методом збереження чоловічого репродуктивного потенціалу. Процедура дозволяє довгостроково зберігати життєздатні сперматозоїди, забезпечуючи можливість запліднення у майбутньому. Детальніше про кріоконсервацію сперми https://icsi.clinic/kriokonservatsiya-spermy у клініці ICSI надається вся необхідна інформація щодо підготовки, проведення та зберігання біологічного матеріалу.
Регулярне оновлення банку сперми та контроль параметрів клітин дозволяє підтримувати високу якість зразків протягом багатьох років. Також рекомендується планувати частоту здачі матеріалу для збільшення доступних запасів сперматозоїдів.
Підготовка до процедури
Перед заморожуванням проводиться комплексне обстеження сперми та загальний аналіз здоров’я пацієнта. В лабораторії оцінюється:
- рухливість;
- концентрація;
- морфологія сперматозоїдів.
Відбір найякісніших клітин дозволяє підвищити ефективність майбутніх процедур запліднення.
Технологія збереження
Кріоконсервація здійснюється за допомогою спеціальних кріопротекторів, які запобігають пошкодженню клітин під час заморожування. Температурний режим контролюється автоматично, що забезпечує збереження життєздатності сперматозоїдів на роки. Використання сучасного обладнання гарантує стабільність умов зберігання та мінімізацію ризиків деградації клітин.
Переваги кріоконсервації
Процедура дозволяє відкласти батьківство на будь-який зручний час, зберегти репродуктивний потенціал перед медичними втручаннями або лікуванням, що може вплинути на фертильність. Кріоконсервація забезпечує доступ до власних сперматозоїдів навіть при зміні стану здоров’я або віку. Репродуктологія у поєднанні з замороженими клітинами гарантує високу ефективність запліднення.
Використання замороженої сперми
При плануванні вагітності використовується розморожена сперма для процедур внутрішньоматкової інсемінації або екстракорпорального запліднення. Контроль якості клітин після розморожування дозволяє вибрати оптимальні зразки для запліднення, що підвищує ймовірність успішної імплантації та розвитку ембріону.
Додаткові аспекти методу
Кріоконсервація сперми у клініці ICSI проводиться з дотриманням високих стандартів безпеки та конфіденційності. Для пацієнтів доступні консультації щодо тривалості зберігання та умов відновлення фертильності. Професійний підхід дозволяє оптимізувати процес відбору та заморожування, забезпечуючи максимальну ефективність майбутніх репродуктивних процедур.
Застосування кріоконсервації сперми відкриває можливість планування батьківства та збереження репродуктивного потенціалу. Клініка ICSI пропонує перевірені технології заморожування, контроль якості та професійний підхід до кожного пацієнта. Цей метод гарантує надійне збереження сперматозоїдів та дозволяє використовувати їх у будь-який зручний час для запліднення.




